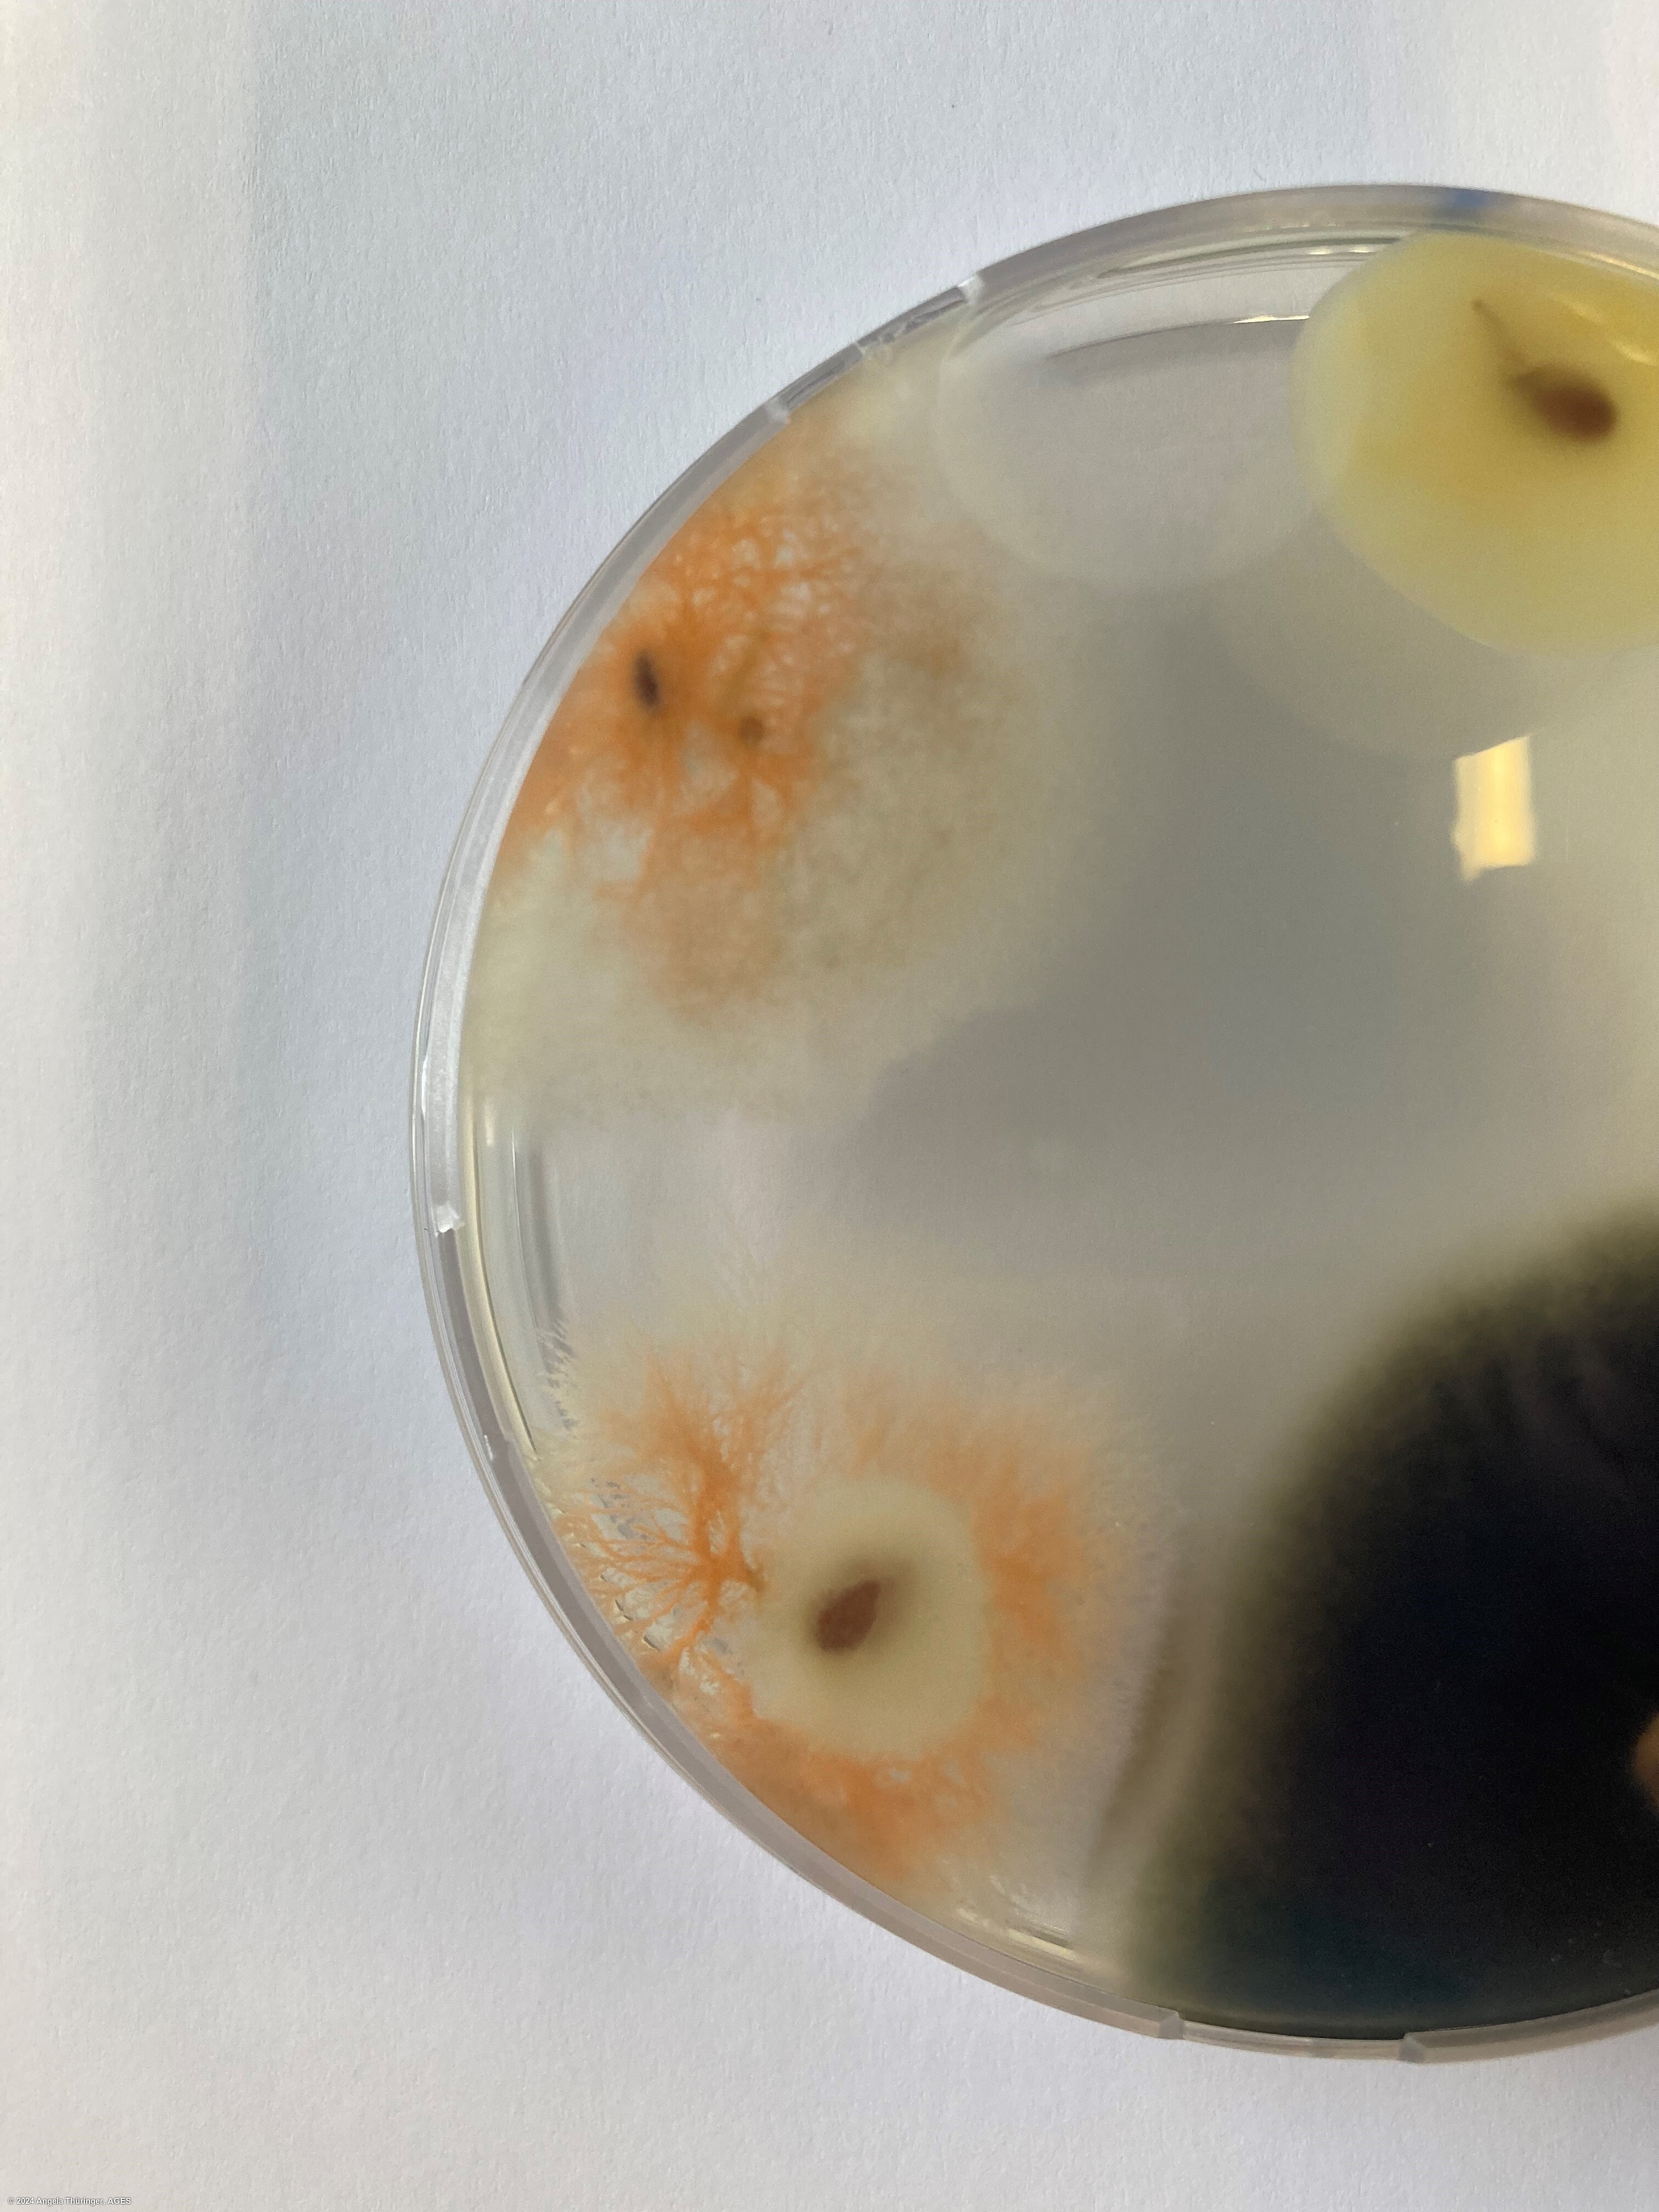

Colletotrichum lini
Overview
|
Scientific name
|
Colletotrichum lini |
|
Genus
|
Colletotrichum |
|
EPPO code
|
COLLLI |
|
Common name
|
Anthracnose |
|
Synonyms
|
Colletotrichum linicola |
Description
ISTA method 7-007, on malt agar: Examine the plates for shell pink to salmon coloured colonies. Colonies of C. lini are a fine woolly-grey at the center to salmon pink at the outer edge. Dark globose fruiting bodies (acervuli) may be scattered throughout the agar adjacent to the seed. Characteristic long, black tapering hairs or setae 2-5 septate, 50-120 x 2-4μm arise from the base of each acervulus. Bright orange conidial masses appear on the seed and agar adjacent to the seed. Conidia re hyaline, oblong to dumbell shaped, one celled, straight end 9-15 x 3-4 μm (Malone & Muskett, 1997; Kulshrestha et al, 1976).
From ISTA's Common Laboratory Seed Health Testing Methods for Detecting Fungi:
Acervuli mostly in groups, rarely single. Setae numerous, but usally one or two emerge from or near the center of the conidial mass. Conidial mass orange to salmon orange. Mycelium scanty, whitish grey to brownish grey. Sclerotia absent.
Conidia hyaline, 1-celled, slightly falcate, often guttulate, ends rounded 11-21 x 3-4μm. Setae filiform, straw coloured to brown, 2-8 septate, 90-150 x 3-4μm.